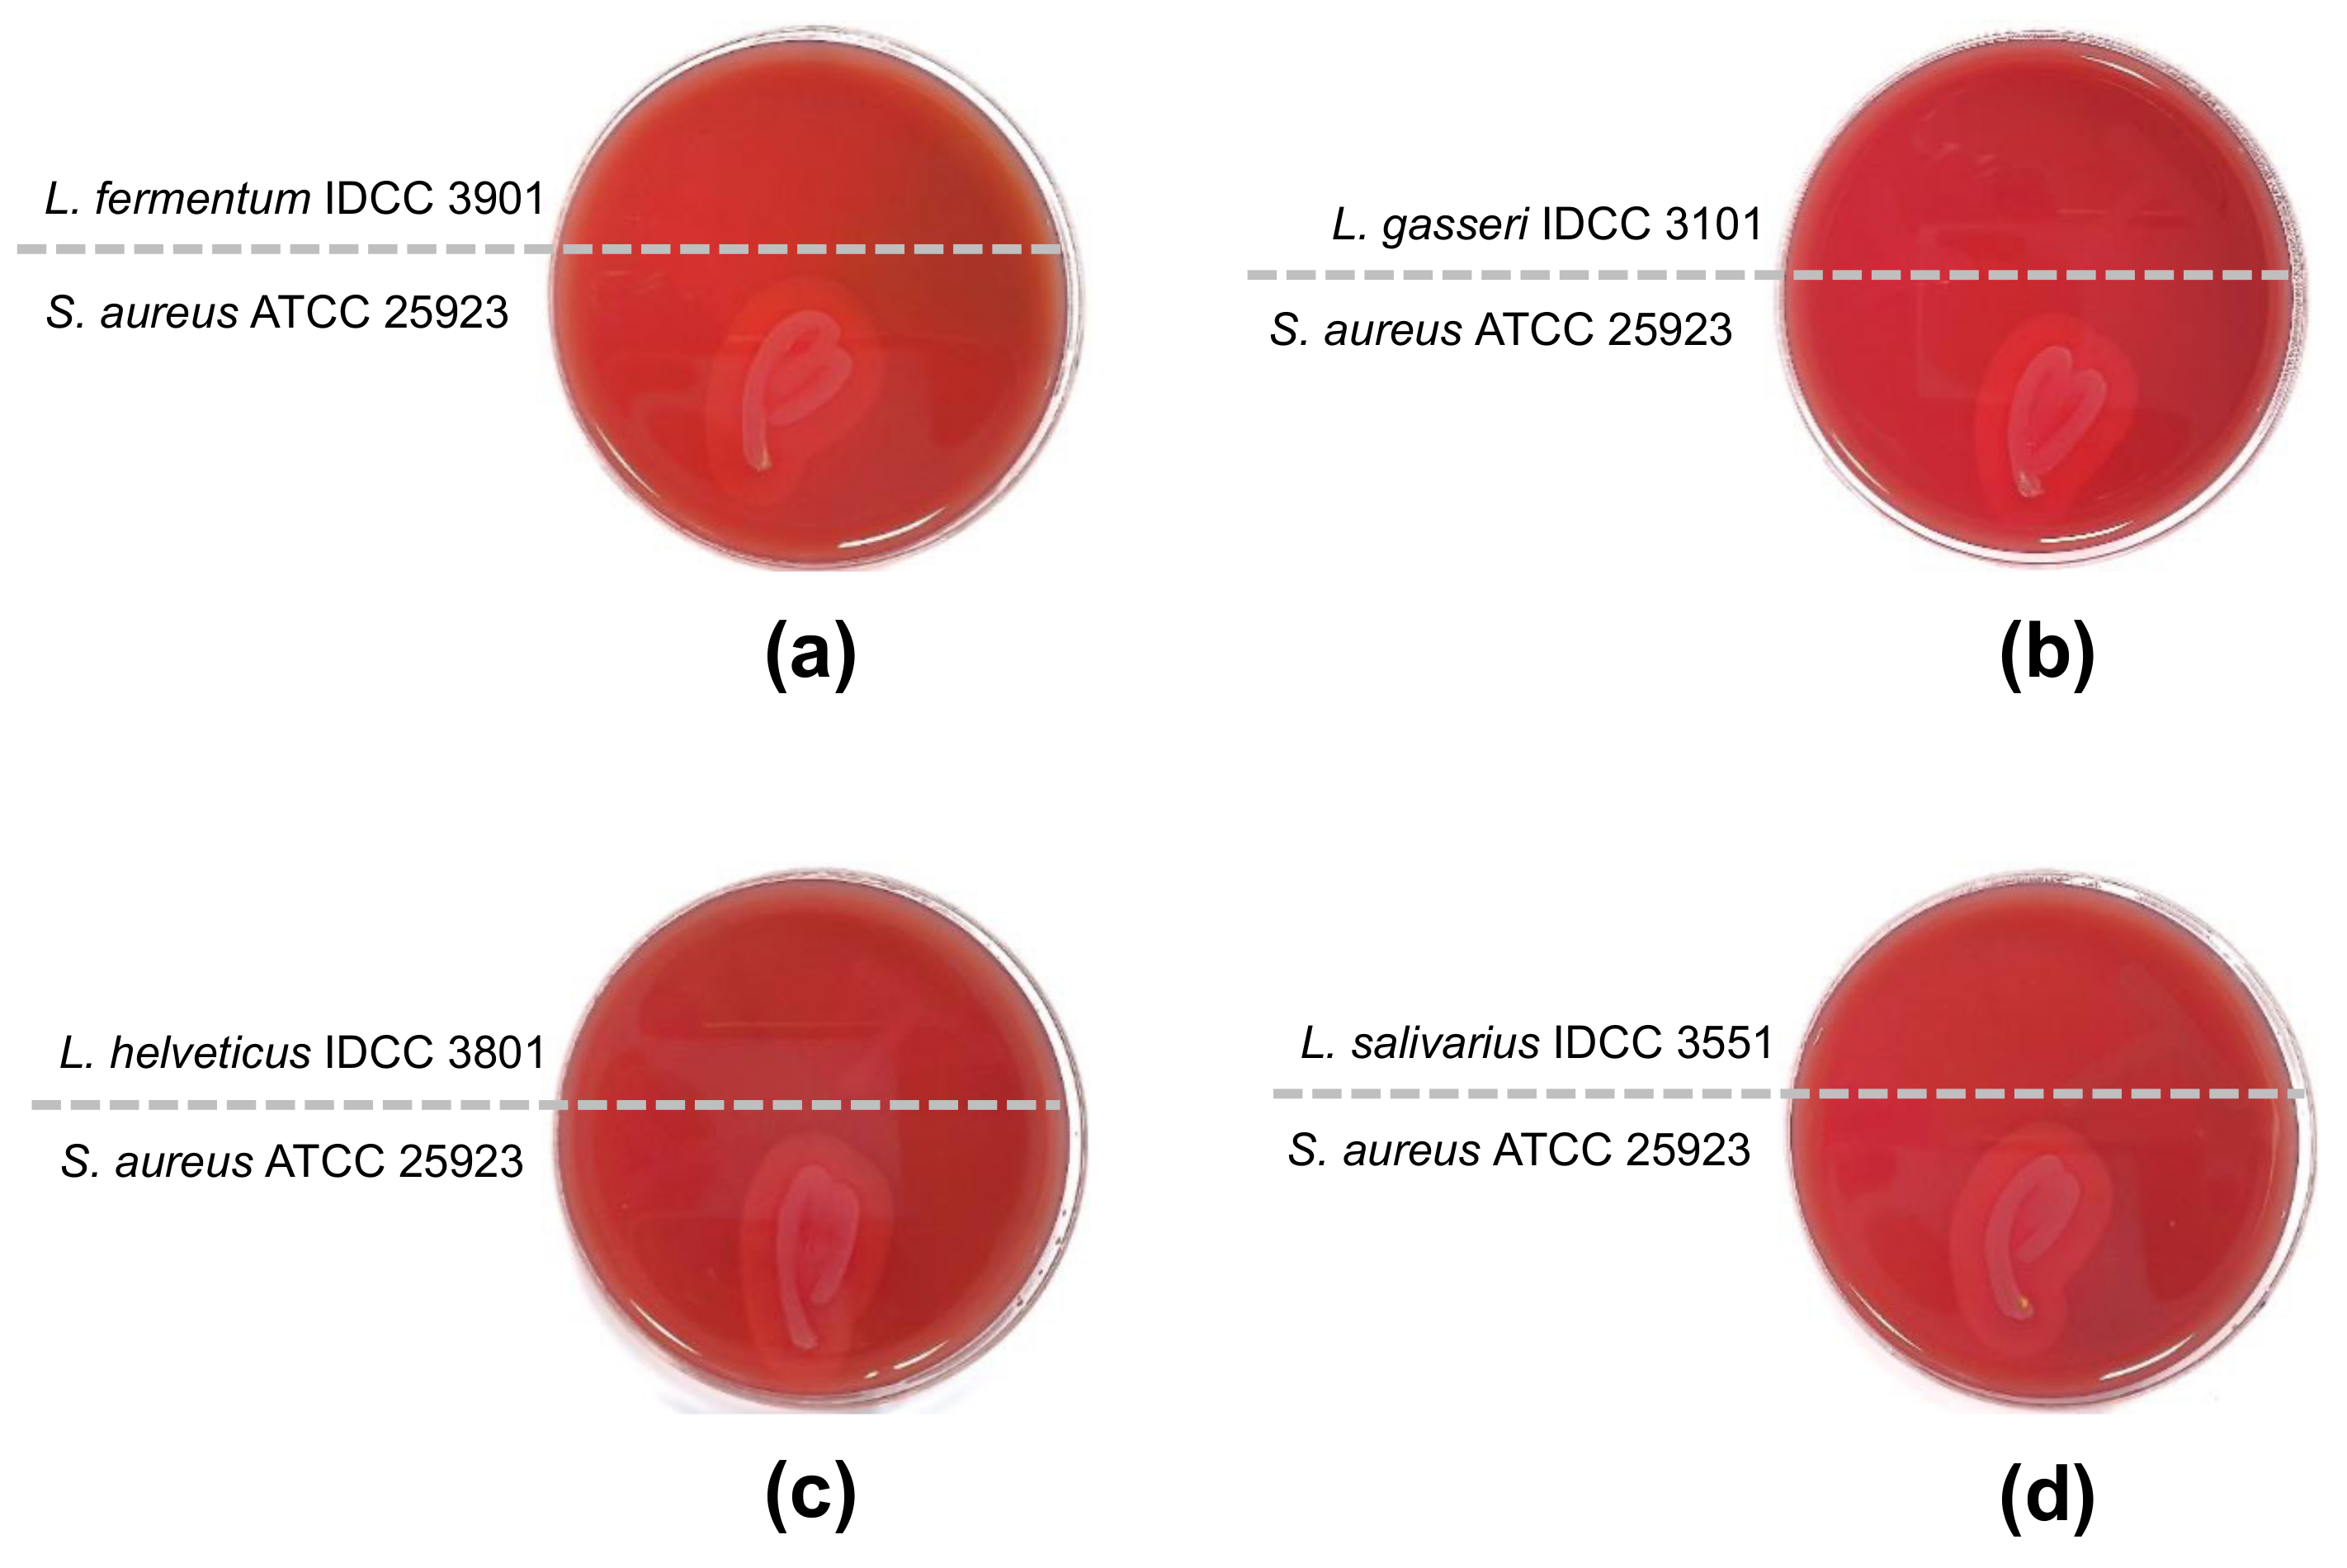
Microorganisms 10 02218 g001

Safety Evaluation by Phenotypic and Genomic Characterization of Four Lactobacilli Strains with Probiotic Properties
Abstract
1. Introduction
2. Materials and Methods
2.1. Bacterial Strains and Growth Conditions
2.2. Genomic Analysis
2.3. Identification of Antibiotic Resistance, Virulence Genes, and Mobile Elements
2.4. Determination of Minimum Inhibitory Concentrations (MICs)
2.5. β-Hemolytic and Enzymatic Activities
2.6. Carbohydrate Utilization
2.7. Biogenic Amine (BA) Production
2.8. D-/L-Lactate Production
2.9. Acute Oral Toxicity
2.10. Antipathogenic Effect
3. Results
3.1. Whole Genome Sequence Analysis
3.2. Determination of MICs
3.3. β-Hemolytic and Enzyme Activity
3.4. Carbohydrate Utilization
3.5. Production of Biogenic Amine and Lactate
3.6. Acute Oral Toxicity
3.7. Antipathogenic Effects of the Four Lactobacillus Strains
4. Discussion
5. Conclusions
Supplementary Materials
Author Contributions
Funding
Data Availability Statement
Conflicts of Interest
References
- Araya, M.; Morelli, L.; Reid, G.; Sanders, M.; Stanton, C.; Pineiro, M.; Ben Embarek, P. Joint FAO/WHO Working Group Report on Drafting Guidelines for the Evaluation of Probiotics in Food; World Health Organization: Geneva: Switzerland; Food and Agriculture Organization of the United Nations: Québec City, QC, Canada, 2002. [Google Scholar]
- Giraffa, G.; Chanishvili, N.; Widyastuti, Y. Importance of lactobacilli in food and feed biotechnology. Res. Microbiol. 2010, 161, 480–487. [Google Scholar] [CrossRef] [PubMed]
- Olson, N.F. The impact of lactic acid bacteria on cheese flavor. FEMS Microbiol. Rev. 1990, 7, 131–147. [Google Scholar] [CrossRef]
- Mohammadi, R.; Sohrabvandi, S.; Mohammad Mortazavian, A. The starter culture characteristics of probiotic microorganisms in fermented milks. Eng. Life Sci. 2012, 12, 399–409. [Google Scholar] [CrossRef]
- Rhee, S.J.; Lee, J.E.; Lee, C.H. Importance of lactic acid bacteria in Asian fermented foods. Microb. Cell Factories 2011, 10 (Suppl. 1), S5. [Google Scholar] [CrossRef] [PubMed]
- Rodas, A.M.; Ferrer, S.; Pardo, I. Polyphasic study of wine Lactobacillus strains: Taxonomic implications. Int. J. Syst. Evol. Microbiol. 2005, 55, 197–207. [Google Scholar] [CrossRef]
- Zhang, Z.; Lv, J.; Pan, L.; Zhang, Y. Roles and applications of probiotic Lactobacillus strains. Appl. Microbiol. Biotechnol. 2018, 102, 8135–8143. [Google Scholar] [CrossRef]
- Van Baarlen, P.; Wells, J.M.; Kleerebezem, M. Regulation of intestinal homeostasis and immunity with probiotic lactobacilli. Trends. Immunol. 2013, 34, 208–215. [Google Scholar] [CrossRef]
- Williams, N.T. Probiotics. Am. J. Health-Syst. Pharm. 2010, 67, 449–458. [Google Scholar] [CrossRef]
- Bang, W.Y.; Kim, H.; Chae, S.A.; Yang, S.Y.; Ban, O.H.; Kim, T.Y.; Kwon, H.S.; Jung, Y.H.; Yang, J. A Quadruple Coating of Probiotics for Enhancing Intestinal Adhesion and Competitive Exclusion of Salmonella typhimurium. J. Med. Food 2022, 25, 213–218. [Google Scholar] [CrossRef]
- Min Cheol, K.; Jin Seok, M.; Young-Hoo, K.; Min-Goo, K.; Tae-Yoon, K.; Ha-Young, P. Analysis of Quadruple Coating for Improvement in Improving Gastrointestinal Stability and Survivability of Probiotics. KSBB J. 2019, 34, 107–113. [Google Scholar] [CrossRef]
- Yeon, S.-W.; You, Y.S.; Kwon, H.-S.; Yang, E.H.; Ryu, J.-S.; Kang, B.H.; Kang, J.-H. Fermented milk of Lactobacillus helveticus IDCC3801 reduces beta-amyloid and attenuates memory deficit. J. Funct. Foods 2010, 2, 143–152. [Google Scholar] [CrossRef]
- Connolly, E.; Abrahamsson, T.; Bjorksten, B. Safety of D(−)-lactic acid producing bacteria in the human infant. J. Pediatr. Gastroenterol. Nutr. 2005, 41, 489–492. [Google Scholar] [CrossRef] [PubMed]
- Chen, L.; Yang, J.; Yu, J.; Yao, Z.; Sun, L.; Shen, Y.; Jin, Q. VFDB: A reference database for bacterial virulence factors. Nucleic Acids Res. 2005, 33, D325–D328. [Google Scholar] [CrossRef] [PubMed]
- Arndt, D.; Grant, J.R.; Marcu, A.; Sajed, T.; Pon, A.; Liang, Y.; Wishart, D.S. PHASTER: A better, faster version of the PHAST phage search tool. Nucleic Acids Res. 2016, 44, W16–W21. [Google Scholar] [CrossRef] [PubMed]
- Campedelli, I.; Mathur, H.; Salvetti, E.; Clarke, S.; Rea, M.C.; Torriani, S.; Ross, R.P.; Hill, C.; O’Toole, P.W. Genus-Wide Assessment of Antibiotic Resistance in Lactobacillus spp. Appl. Env. Microbiol. 2019, 85, e01738-18. [Google Scholar] [CrossRef] [PubMed]
- Kim, D.H.; Jin, Y.H. Intestinal bacterial beta-glucuronidase activity of patients with colon cancer. Arch. Pharmacal Res. 2001, 24, 564–567. [Google Scholar] [CrossRef] [PubMed]
- Ruiz-Capillas, C.; Herrero, A.M. Impact of Biogenic Amines on Food Quality and Safety. Foods 2019, 8, 62. [Google Scholar] [CrossRef]
- Kandler, O. Carbohydrate metabolism in lactic acid bacteria. Antonie Van Leeuwenhoek 1983, 49, 209–224. [Google Scholar] [CrossRef]
- Petersen, C. D-lactic acidosis. Nutr. Clin. Pr. 2005, 20, 634–645. [Google Scholar] [CrossRef]
- Georgieva, R.; Yocheva, L.; Tserovska, L.; Zhelezova, G.; Stefanova, N.; Atanasova, A.; Danguleva, A.; Ivanova, G.; Karapetkov, N.; Rumyan, N.; et al. Antimicrobial activity and antibiotic susceptibility of Lactobacillus and Bifidobacterium spp. intended for use as starter and probiotic cultures. Biotechnol. Biotechnol. Equip. 2015, 29, 84–91. [Google Scholar] [CrossRef]
- Cortesia, C.; Vilchèze, C.; Bernut, A.; Contreras, W.; Gómez, K.; Waard, J.d.; Jacobs, W.R.; Kremer, L.; Takiff, H. Acetic Acid, the Active Component of Vinegar, Is an Effective Tuberculocidal Disinfectant. mBio 2014, 5, e00013–e00014. [Google Scholar] [CrossRef] [PubMed]
- Karpiński, T.M.; Szkaradkiewicz, A.K. Characteristic of bacteriocines and their application. Pol. J. Microbiol. 2013, 62, 223–235. [Google Scholar] [CrossRef] [PubMed]
- Gorbach, S.L. Microbiology of the Gastrointestinal Tract. In Medical Microbiology; Baron, S., Ed.; University of Texas Medical Branch at Galveston: Galveston, TX, USA, 1996. [Google Scholar]
- Dasaraju, P.V.; Liu, C. Infections of the respiratory system. In Medical Microbiology, 4th ed.; University of Texas Medical Branch at Galveston: Galveston, TX, USA, 1996; pp. 312–344. [Google Scholar]
- Klare, I.; Konstabel, C.; Werner, G.; Huys, G.; Vankerckhoven, V.; Kahlmeter, G.; Hildebrandt, B.; Muller-Bertling, S.; Witte, W.; Goossens, H. Antimicrobial susceptibilities of Lactobacillus, Pediococcus and Lactococcus human isolates and cultures intended for probiotic or nutritional use. J. Antimicrob. Chemother. 2007, 59, 900–912. [Google Scholar] [CrossRef] [PubMed]
- Salminen, M.K.; Rautelin, H.; Tynkkynen, S.; Poussa, T.; Saxelin, M.; Valtonen, V.; Jarvinen, A. Lactobacillus bacteremia, species identification, and antimicrobial susceptibility of 85 blood isolates. Clin. Infect. Dis. 2006, 42, e35–e44. [Google Scholar] [CrossRef] [PubMed]
- Kim, H.; Chae, S.; Lee, M.; Yang, S.-Y.; Ban, O.H.; Jung, Y.H.; Yang, J. Genomic and Toxicity Studies on Bifidobacterium longum IDCC 4101 and Bifidobacterium bifidum IDCC 4201 Isolated from Feces of Breast-Fed Infants. Food Suppl. Biomater. Health 2021, 1, e37. [Google Scholar] [CrossRef]
- Louis, P.; Hold, G.L.; Flint, H.J. The gut microbiota, bacterial metabolites and colorectal cancer. Nat. Rev. Microbiol. 2014, 12, 661–672. [Google Scholar] [CrossRef] [PubMed]
- Wojcik, W.; Lukasiewicz, M.; Puppel, K. Biogenic amines: Formation, action and toxicity—A review. J. Sci. Food Agric. 2021, 101, 2634–2640. [Google Scholar] [CrossRef] [PubMed]
- Shin, M.; Ban, O.H.; Jung, Y.H.; Yang, J.; Kim, Y. Genomic characterization and probiotic potential of Lactobacillus casei IDCC 3451 isolated from infant faeces. Lett. Appl. Microbiol. 2021, 72, 578–588. [Google Scholar] [CrossRef]

| Strain | Origin | ATCC Number |
|---|---|---|
| Lactobacillus fermentum IDCC 3901 | Homemade cheese | BAA-2842 |
| Lactobacillus gasseri IDCC 3101 | Breast milk | BAA-2841 |
| Lactobacillus helveticus IDCC 3801 | Breast-fed infant feces | BAA-2840 |
| Lactobacillus salivarius IDCC 3551 | Healthy child saliva | BAA-2835 |
| Strain | Culture Condition |
|---|---|
| Staphylococcus aureus ATCC 25923 | TSB medium (BD Difco), 37 °C, 24 h, aerobic |
| Enterococcus faecalis ATCC 29212 | BHI medium (BD Difco), 37 °C, 24 h, aerobic |
| Streptococcus pneumoniae ATCC 49619 | BHI medium, 37°C, 24 h, aerobic |
| Bacillus cereus ATCC 14579 | Nutrient medium (BD Difco), 30 °C, 24 h, aerobic |
| Salmonella Typhimurium ATCC 13311 | Nutrient medium, 37°C, 24 h, aerobic |
| Lactobacillus fermentum IDCC 3901 | Lactobacillus gasseri IDCC 3101 | Lactobacillus helveticus IDCC 3801 | Lactobacillus salivarius IDCC 3551 | |
|---|---|---|---|---|
| Identification | Limosilactobacillus fermentum | Lactobacillus gasseri | Lactobacillus helveticus | Lactobacillus salivarius |
| Genome size (bp) | 2,094,262 | 2,167,634 | 2,204,078 | 1,507,589 |
| GC contents (%) | 51.81 | 34.72 | 36.81 | 32.89 |
| CDS | 2051 | 2185 | 2085 | 1309 |
| ANI value (%) | 99.35 | 99.91 | 98.16 | 99.98 |
| Strain | Items | Antibiotics 1 | ||||||||
|---|---|---|---|---|---|---|---|---|---|---|
| AMP | VAN | GEN | KAN | STR | ERY | CLI | TET | CHL | ||
| L. fermentum IDCC 3901 | Cut-off value (µg/mL) 2 | 2 | n.r. 3 | 16 | 64 | 64 | 1 | 4 | 8 | 4 |
| Observed MIC | <0.125 | 512> | 64 | 256 | 128 | 0.25 | <0.125 | 2 | 4 | |
| Assessment | S 4 | n.r. | R 5 | R | R | S | S | S | S | |
| Antibiotic resistance gene | n.d. 6 | n.d. | n.d. | n.d. | n.d. | n.d. | n.d. | n.d. | n.d. | |
| L. gasseri IDCC 3101 | Cut-off value (µg/mL) 2 | 1 | 2 | 16 | 64 | 16 | 1 | 4 | 4 | 4 |
| Observed MIC | 0.5 | 2 | 256 | 512> | 256 | <0.125 | 4 | 1 | 4 | |
| Assessment | S | S | R | R | R | S | S | S | S | |
| Antibiotic resistance gene | n.d. | n.d. | n.d. | n.d. | n.d. | n.d. | n.d. | n.d. | n.d. | |
| L. helveticus IDCC 3801 | Cut-off value (µg/mL) 2 | 2 | 2 | 16 | 16 | 16 | 1 | 4 | 4 | 4 |
| Observed MIC | <0.125 | 1 | 64 | 128 | 8 | <0.125 | 1 | 0.5 | 2 | |
| Assessment | S | S | R | R | S | S | S | S | S | |
| Antibiotic resistance gene | n.d. | n.d. | n.d. | n.d. | n.d. | n.d. | n.d. | n.d. | n.d. | |
| L. salivarius IDCC 3551 | Cut-off value (µg/mL) 2 | 4 | n.r. | 16 | 64 | 64 | 1 | 4 | 8 | 4 |
| Observed MIC | 0.25-0.5 | 512> | 32 | 512> | 256 | 0.25 | 0.25 | 1 | 2 | |
| Assessment | S | n.r. | R | R | R | S | S | S | S | |
| Antibiotic resistance gene | n.d. | n.d. | n.d. | n.d. | n.d. | n.d. | n.d. | n.d. | n.d. | |
| L. fermentum IDCC 3901 | L. gasseri IDCC 3101 | L. helveticus IDCC 3801 | L. salivarius IDCC 3551 | |
|---|---|---|---|---|
| Alkaline phosphatase | − | − | − | − |
| Esterase | + | + | + | − |
| Esterase lipase | − | − | − | − |
| Lipase | − | − | − | − |
| Leucine arylamidase | + | + | + | + |
| Valine arylamidase | + | − | − | + |
| Cystine arylamidase | − | − | + | + |
| Trypsin | − | − | − | − |
| α-Chymotrypsin | − | − | − | − |
| Acid phosphatase | + | + | + | + |
| Naphthol-AS-BI-phosphohydrolase | − | + | + | + |
| α-Galactosidase | + | + | − | + |
| β-Galactosidase | + | + | + | + |
| β-Glucuronidase | − | − | − | − |
| α-Glucosidase | + | − | − | − |
| β-Glucosidase | − | + | + | − |
| N-Acetyl-β-glucosaminidase | − | + | − | − |
| α-Mannosidase | − | − | − | − |
| α-Fucosidase | − | − | − | − |
| L. fermentum IDCC 3901 | L. gasseri IDCC 3101 | L. helveticus IDCC 3801 | L. salivarius IDCC 3551 | |
|---|---|---|---|---|
| Glycerol | − | − | − | − |
| Erythritol | − | − | − | − |
| D-Arabinose | − | − | − | − |
| L-Arabinose | + | − | − | − |
| Ribose | + | − | − | − |
| D-Xylose | − | − | − | − |
| L-Xilose | − | − | − | − |
| Adonitol | − | − | − | − |
| β-Methyl-xylose | − | − | − | − |
| Galactose | + | + | + | + |
| D-Glucose | + | + | + | + |
| D-Fructose | + w | + | + | + |
| D-Mannose | − | + | + | + |
| L-Sorbose | − | − | − | − |
| Rhamnose | − | − | − | − |
| Dulcitol | − | − | − | − |
| Inositiol | − | − | − | − |
| Mannitol | − | − | − | + |
| Sorbitol | − | − | − | + |
| α-Methyl-D-mannoside | − | − | − | − |
| α-Methyl-D-glucoside | − | − | − | − |
| N-Acethyl-Glucosamine | − | + | + | + |
| Amygdaline | − | + w | + | − |
| Arbutine | − | + | + | + |
| Esculine | + | + | + | + |
| Salicine | − | + | + | + |
| Cellobiose | − | + | + | − |
| Maltose | + | + | + | + |
| Lactose | + | + | + | + |
| Melibiose | + | − | − | + |
| Sucrose | + | + | + | + |
| Trehalose | − | + | + | + |
| Inuline | − | − | − | − |
| Melizitose | − | − | − | − |
| D-Raffinose | + | − | − | + |
| Amidon | − | + w | + w | − |
| Glycogene | − | − | − | − |
| Xylitol | − | − | − | − |
| Gentibiose | − | + | + | − |
| D-Turanose | − | + | − | − |
| D-Lyxose | − | − | − | − |
| D-Tagatose | − | + | − | − |
| D-Fucose | − | − | − | − |
| L-Fucose | − | − | − | − |
| D-Arabitol | − | − | − | − |
| L-Arabitol | − | − | − | + |
| Gluconate | + w | − | − | − |
| 2-keto-gluconate | − | − | − | − |
| 5-keto-gluconate | + w | − | − | − |
| Strains | Group | Dose (g/kg BW 1) | Day after Administration | ||||
|---|---|---|---|---|---|---|---|
| 0 | 1 | 3 | 7 | 14 | |||
| L. fermentum 2232IDCC 3901 | 9 weeks old | 300 | 216.0 ± 2.9 | 233.0 ± 11.5 | 246.4 ± 12.5 | 257.4 ± 20.3 | 264.1 ± 13.3 |
| 2000 | 209.9 ± 8.6 | 231.4 ± 12.6 | 235.3 ± 15.0 | 243.1 ± 16.9 | 253.3 ± 12.4 | ||
| 10 weeks old | 300 | 226.4 ± 3.0 | 248.5 ± 9.6 | 251.9 ± 6.5 | 260.3 ± 5.3 | 268.7 ± 4.4 | |
| 2000 | 217.6 ± 10.7 | 240.6 ± 10.0 | 246.7 ± 9.1 | 252.9 ± 13.3 | 260.2 ± 18.2 | ||
| L. gasseri 2232IDCC 3101 | 9 weeks old | 300 | 216.6 ± 14.5 | 231.9 ± 11.6 | 248.6 ± 10.6 | 259.2 ± 11.1 | 270.9 ± 16.0 |
| 2000 | 202.3 ± 3.2 | 224.7 ± 9.9 | 230.8 ± 8.0 | 236.8 ± 11.4 | 251.6 ± 4.9 | ||
| 10 weeks old | 300 | 225.0 ± 3.7 | 241.5 ± 9.6 | 257.9 ± 8.5 | 259.6 ± 2.9 | 270.8 ± 6.3 | |
| 2000 | 222.1 ± 4.1 | 251.6 ± 7.0 | 257.6 ± 6.0 | 265.0 ± 4.3 | 269.0 ± 6.7 | ||
| L. helveticus 2302IDCC 3801 | 9 weeks old | 300 | 222.6 ± 8.6 | 247.2 ± 8.3 | 255.8 ± 4.8 | 270.4 ± 10.9 | 279.1 ± 14.0 |
| 2000 | 217.1 ± 5.1 | 231.7 ± 6.1 | 237.8 ± 1.9 | 243.8 ± 8.2 | 254.5 ± 7.5 | ||
| 10 weeks old | 300 | 245.3 ± 5.3 | 268.5 ± 7.7 | 273.5 ± 5.2 | 277.6 ± 10.5 | 294.3 ± 11.4 | |
| 2000 | 222.2 ± 4.2 | 242.7 ± 10.5 | 254.2 ± 8.0 | 264.5 ± 4.1 | 271.2 ± 9.5 | ||
| L. salivarius IDCC 3551 | 9 weeks old | 300 | 207.6 ± 3.8 | 231.4 ± 5.4 | 236.4 ± 1.4 | 241.6 ± 2.1 | 264.4 ± 2.8 |
| 2000 | 209.1 ± 7.2 | 234.7 ± 9.3 | 237.7 ± 9.3 | 250.8 ± 13.8 | 259.2 ± 15.7 | ||
| 10 weeks old | 300 | 222.8 ± 5.4 | 245.5 ± 6.5 | 251.6 ± 1.3 | 262.3 ± 2.0 | 269.6 ± 5.5 | |
| 2000 | 218.5 ± 5.1 | 244.3 ± 5.6 | 248.5 ± 0.8 | 258.2 ± 0.8 | 266.1 ± 4.1 | ||
Publisher’s Note: MDPI stays neutral with regard to jurisdictional claims in published maps and institutional affiliations. |
© 2022 by the authors. Licensee MDPI, Basel, Switzerland. This article is an open access article distributed under the terms and conditions of the Creative Commons Attribution (CC BY) license (https://creativecommons.org/licenses/by/4.0/).
Share and Cite
Lee, Y.-R.; Bang, W.Y.; Baek, K.-R.; Kim, G.-H.; Kang, M.-J.; Yang, J.; Seo, S.-O. Safety Evaluation by Phenotypic and Genomic Characterization of Four Lactobacilli Strains with Probiotic Properties. Microorganisms 2022, 10, 2218. https://doi.org/10.3390/microorganisms10112218
Lee Y-R, Bang WY, Baek K-R, Kim G-H, Kang M-J, Yang J, Seo S-O. Safety Evaluation by Phenotypic and Genomic Characterization of Four Lactobacilli Strains with Probiotic Properties. Microorganisms. 2022; 10(11):2218. https://doi.org/10.3390/microorganisms10112218
Chicago/Turabian StyleLee, Ye-Rim, Won Yeong Bang, Kwang-Rim Baek, Geun-Hyung Kim, Min-Ji Kang, Jungwoo Yang, and Seung-Oh Seo. 2022. "Safety Evaluation by Phenotypic and Genomic Characterization of Four Lactobacilli Strains with Probiotic Properties" Microorganisms 10, no. 11: 2218. https://doi.org/10.3390/microorganisms10112218
APA StyleLee, Y.-R., Bang, W. Y., Baek, K.-R., Kim, G.-H., Kang, M.-J., Yang, J., & Seo, S.-O. (2022). Safety Evaluation by Phenotypic and Genomic Characterization of Four Lactobacilli Strains with Probiotic Properties. Microorganisms, 10(11), 2218. https://doi.org/10.3390/microorganisms10112218

